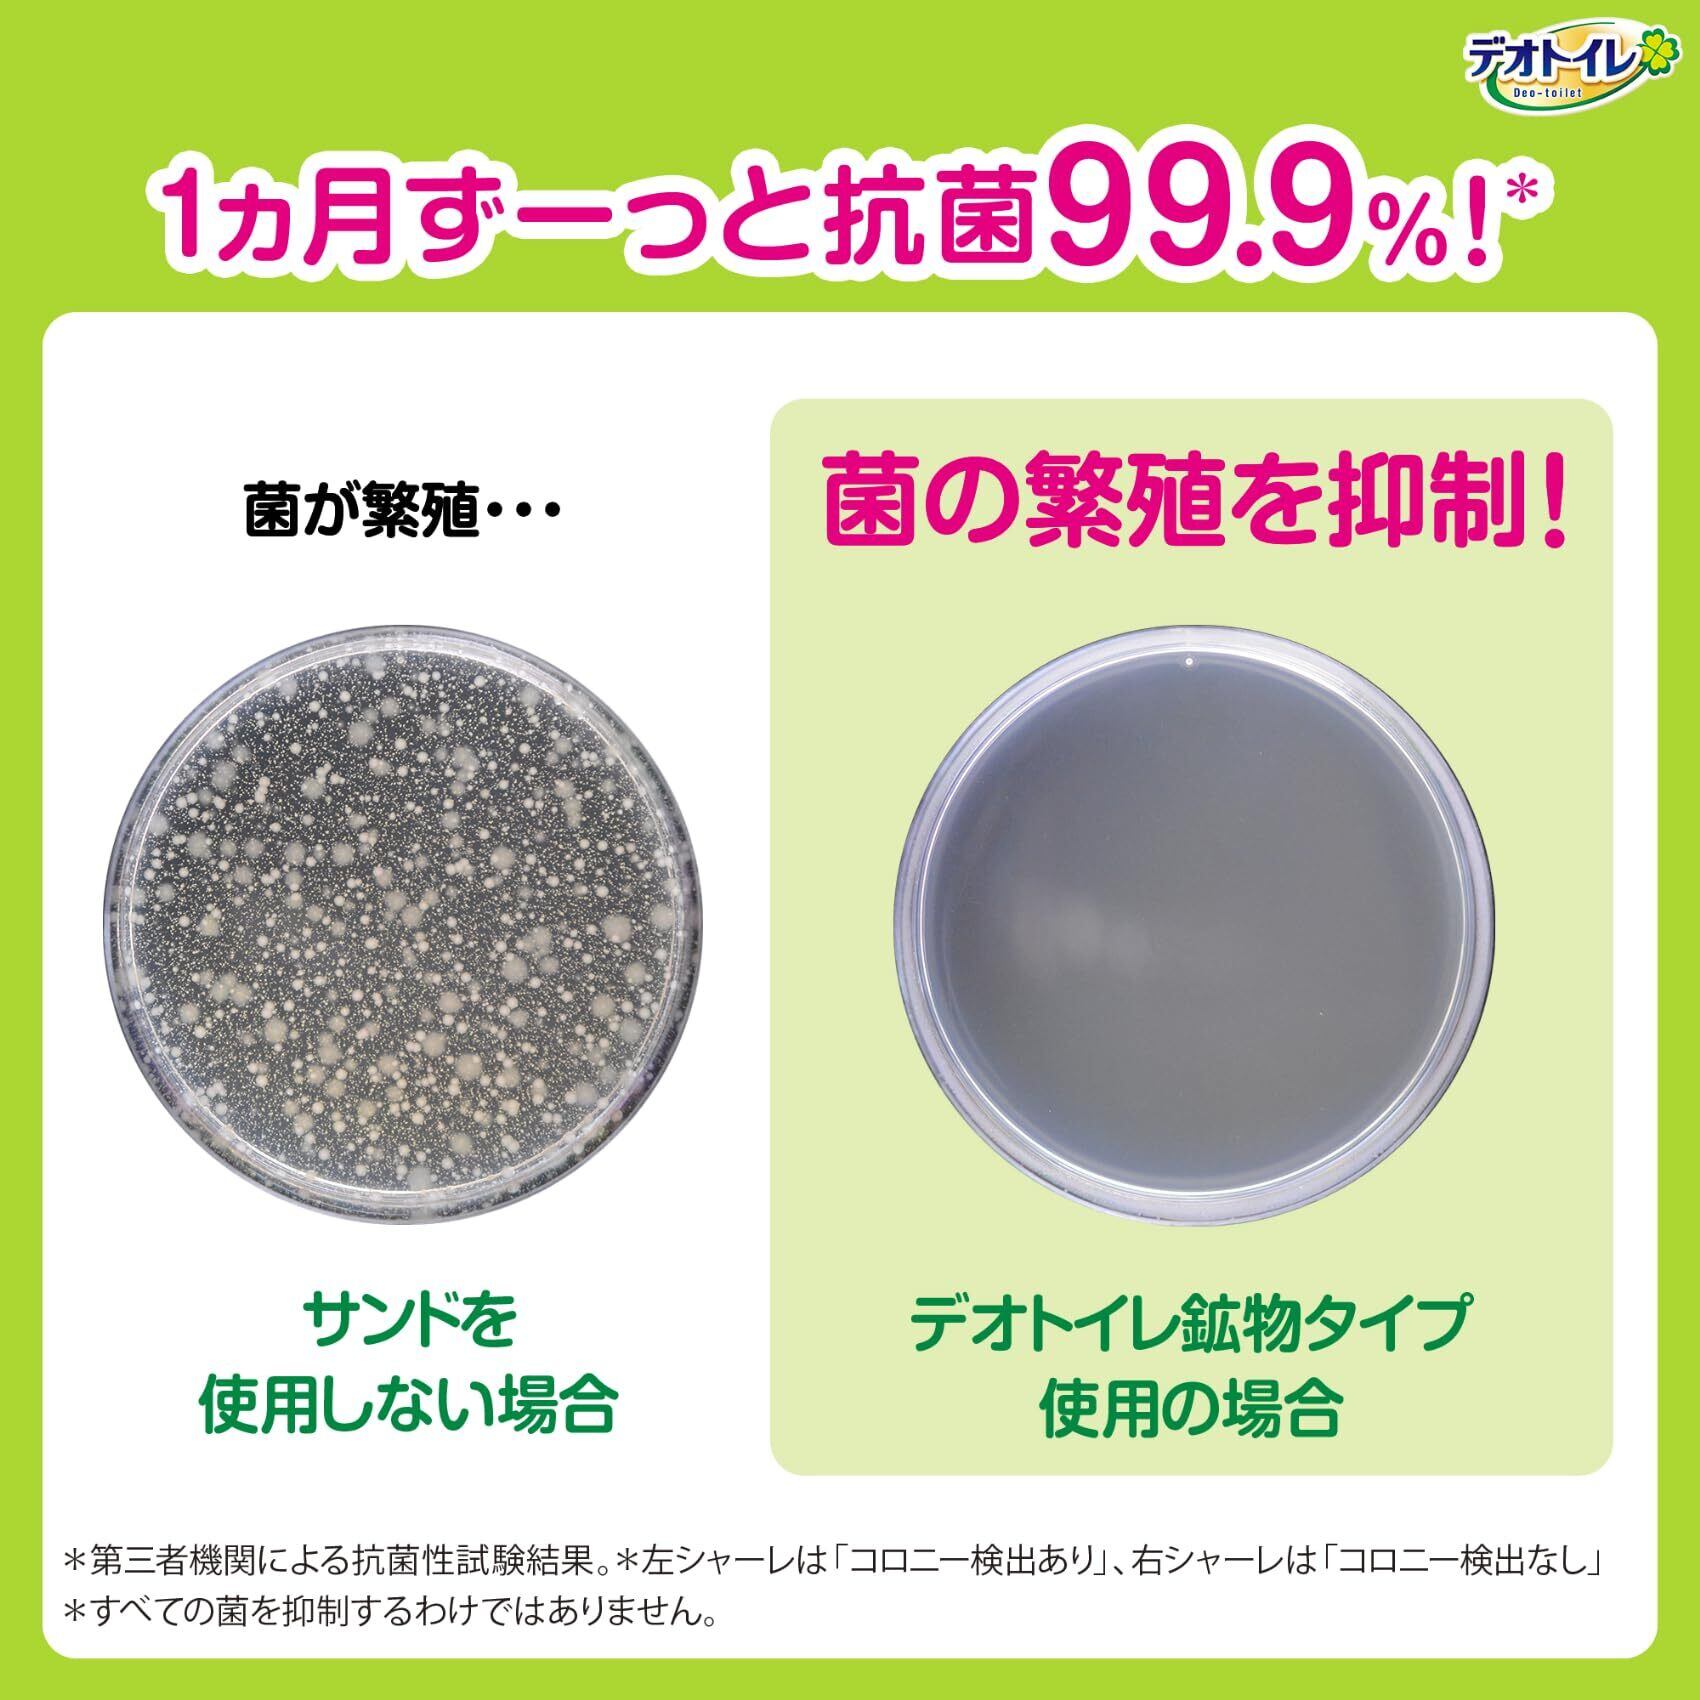

【特価セール】【無菌レベルでニオわない】デオトイレ 消臭・抗菌サンド [ニオイ菌99.9%抑制] 4.5L [猫砂] システムトイレ 猫用【限定】
¥2,131
残り1点
International shipping available
ご覧いただきありがとうございます。
当店では他サイトにも商品を販売しているため
まれに売れ残りや取り寄せ中となる場合がありますがご了承ください。
【商品名】
【無菌レベルでニオわない】デオトイレ 消臭・抗菌サンド [ニオイ菌99.9%抑制] 4.5L [猫砂] システムトイレ 猫用【限定】
【商品説明】
トイレタリーグッズ ねこちゃん用システムトイレ
無菌レベルでニオわない※1 ※2 猫トイレ(無菌レベルとは、ニオイ菌を検出限界以下に抑制すること)
※1愛猫1頭(体重8kgまで)のデオトイレ使用時。ウンチをした場合は早く取り除いてください。普段の生活での消費者テストにて「トイレに近づいてもニオわない」と回答した消費者84.8%、外部機関におけるアンモニア濃度試験を実施、また、臭気判定士による臭気強度評価を実施。
※2ニオイ菌とはオシッコからアンモニアを発生させやすい菌のこと。第三者機関による抗菌性試験結果。すべての菌を抑制するわけではありません。
撥水サンドで、サンド表面にオシッコ汚れを残さず通過し、ニオわない。※3 ※3オシッコ汚れとはサンド表面に残ったオシッコ液のこと
ミクロの穴でニオイを吸着して強力消臭
1ヶ月交換不要※4 ※4愛猫1頭(体重8kgまで)のデオトイレ使用時。ウンチをした場合は早く取り除いてください
・撥水サンドで、サンド表面にオシッコ汚れを残さず通過し、ニオわない。*1・ミクロの穴でニオイを吸着して強力消臭・1ヶ月交換不要*2・手足に挟まりにくい大きさで、飛び散りにくい*3・粉立ちカットコーティング採用*1オシッコ汚れとはサンド表面に残ったオシッコ液のこと*2愛猫1頭(体重8kgまで)のデオトイレ使用時。ウンチをした場合は早く取り除いてください*3デオサンド比
使用方法
・本品は直射日光、高温多湿を避けて食器・おもちゃ・ペットフード等と区別し、小児の手の届かない場所に保管してください。また、開封後はほこりや虫が入らないよう封をしっかり閉じて保管し、お早めにご使用ください。 ・本品の空袋をおもちゃにしないでください。・本品は『デオトイレ』専用です。用途以外には使用しないでください。 ・『デオトイレ』専用品以外のものをお使いいただくと、消臭・抗菌の性能が十分に発揮できない場合があります。 ・本品は食べられません。飲み込んだ場合は医師や獣医師にご相談ください。 ・万一、サンドがトイレから飛び散ったときは、すぐに片づけてください。足をすべらせる恐れがあります。 ・本品が万が一、人の目に入った場合は流水で洗い流し、医師にご相談ください。動物の目に入った場合は、獣医師にご相談ください。 ・本品はトイレに流さず、処理方法は居住地域のルールに従ってください。
最後までご確認いただきありがとうございます。
上記をご確認いただき、ご購入いただましたら幸いです。
なにかご不明な点がございましたらお気軽にメッセージからお問い合わせください。
-
レビュー
(14)